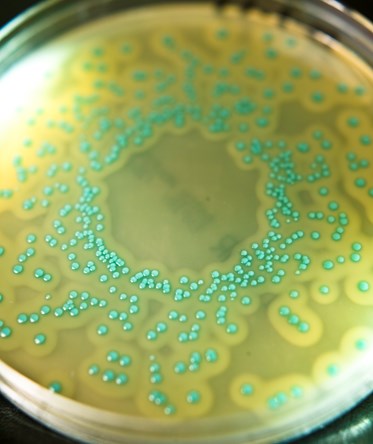
Listeria monocytogenes plate

The National Collection of Type Cultures (NCTC)
We supply over 5,800 type and reference bacterial strains, many of which are of global importance in medical, scientific, and veterinary fields.
Founded in 1920, the National Collection of Type Cultures (NCTC) is the world’s longest-established bacterial culture collection. It also serves as a UNESCO Microbial Resource Centre (MIRCEN). Our strains support institutions across academia, healthcare, food safety, and veterinary science, and are used in microbiology laboratories and research institutes worldwide.
Certified to ISO/IEC 17025:2017, NCTC is one of the four Culture Collections of the UK Health Security Agency (UKHSA). We benefit from the expertise of UKHSA’s internationally recognised specialists in clinical, food, water, and environmental microbiology, genomics, and proteomics.
NCTC also provide several specialist services, including our role as an International Depository Authority (IDA) for patenting bacterial cultures.
Products
NCTC strains are a vital resource for the life sciences community. Many are included in internationally recognised standard methods as definitive control strains for microbiological testing. The collection features species from diverse geographic regions and disease conditions, including strains with known antimicrobial resistance mechanisms or specific plasmids.
Culture Storage
All strains are:
-
Characterised and authenticated
-
Preserved as freeze-dried (lyophilised) cultures
-
Sealed in fused-glass ampoules
-
Stored primarily at 4-10°C
Bacterial DNA
High molecular weight DNA (approx. 2µg) is available from selected strains, suitable for molecular applications including whole genome sequencing.
Microbiological Reference Materials
NCTC LENTICULE® discs, now manufactured by Merck (previously Sigma-Aldrich) .provide internal quality control for microbiological testing. LENTICULE® is a trademark of UKHSA, and both the discs and preparation method are protected under International Patent Application WO 01/05941.
Specialised Strain Collections
We offer grouped strains for specific applications:
-
Antimicrobial susceptibility control strains and antimicrobial resistance reference strains (view the brochure)
-
Control strains for water testing (e.g., Pseudomonas aeruginosa)
-
Clostridium difficile strains (ribotype and toxin status)
-
NCTC reference strains for UK Standards for Microbiology Investigations (UK-SMI)
-
World Data Centre for Microorganisms (WDCM) reference strains
Supply Restrictions
Certain highly pathogenic strains are subject to supply restrictions.
Registration is required for individuals and organisations requesting access to restricted strains.
Authorisation to access restricted pathogens registration form

Bacterial DNA

Bacteriophage

Freeze-drying service
There are several ways to find out more about NCTC. You can follow us on X (twitter), read our latest newsletters or take a look at our brochures.

Follow us on X

NCTC News

FAQs
NCTC is a registered trademark of the UK Health Security Agency in the UK. The trademark must not be used without a license agreement. Parties interested in using the trademarks should contact us.